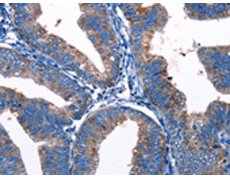
一抗

中文名稱: 兔抗Gjc3多克隆抗體
|
Background: |
Gap junction gamma-3, also known as connexin-30.2 (Cx30.2) or connexin-31.3 (Cx31.3) or gap junction epsilon-1 (GJE1), is a protein that in humans is encoded by the GJC3 gene. GJC3 is a connexin. This gene encodes a gap junction protein. The encoded protein, also known as a connexin, plays a role in formation of gap junctions, which provide direct connections between neighboring cells. Mutations in this gene have been reported to be associated with nonsyndromic hearing loss. |
|
Applications: |
ELISA, IHC |
|
Name of antibody: |
Gjc3 |
|
Immunogen: |
Synthetic peptide of mouse Gjc3 |
|
Full name: |
gap junction protein, gamma 3 |
|
Synonyms: |
Cx29, Gje1 |
|
SwissProt: |
Q921C1 |
|
ELISA Recommended dilution: |
1000-2000 |
|
IHC positive control: |
Human cervical cancer and Human colon cancer |
|
IHC Recommend dilution: |
10-50 |

 購(gòu)物車
購(gòu)物車 幫助
幫助
 021-54845833/15800441009
021-54845833/15800441009